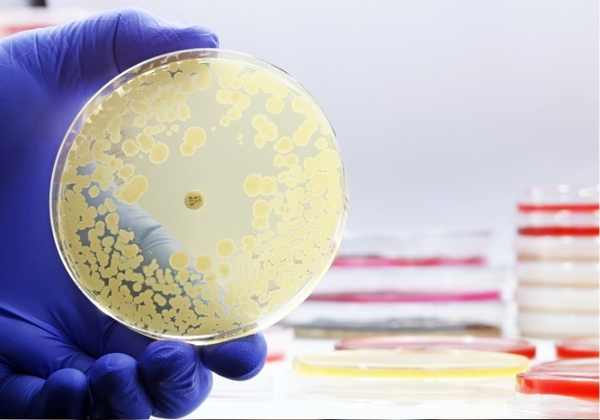
Study on a critical antibiotic: Ciprofloxacin

BioChemistry & Pharmacology
Understand how the molecules in your body work together and interact with different chemicals to influence health and diseases
Introduction
Whether you are considering a career in health sciences or are simply curious about the science of life, this course will equip you with the knowledge to understand the molecular basis of health and medicine.
The Nobel Prize in chemistry was awarded in 2024 to David Baker, Demis Hassabis and John Jumper for their breakthrough work predicting and designing the structure of proteins, the building blocks of life.
Curriculum: Course Code: AT-055
Various modules focus on how key biomolecules such as proteins, lipids, carbohydrates, and nucleic acids, as well as enzymatic functions, metabolic pathways, and molecular interactions get perturbed in various diseases. Ongoing advancements in pharmacology are driving innovations in diagnostics, treatments, and personalized medicine, leading to improved healthcare outcomes and the development of more effective therapies for a variety of conditions.
Pharmacology delves into drug classification of key drug targets like enzymes and ion channels, how drugs act on the disease, how it moves through the body, mechanism of action, how it's broken down (metabolized), and how it's eventually removed.
Case studies are integrated to connect biomedical chemistry and pharmacology concepts to practical applications, fostering a deeper understanding of disease biology and therapeutic strategies. This course combines foundational knowledge with real-world insights to prepare students for advanced studies.
Capstone Project
Highlights
- •Biomolecules and metabolic pathways
- •Molecular interactions and Drugs mechanism of action
- •Pharmacokinetics and Pharmacodynamics
- •Drug development and Innovations in personalized medicine
- •Practical applications and careers in pharmaceutical sciences
Career counseling about an increasingly wide range of available careers, including research (academic & Pharmaceutical company based), teaching, Medical practitioners, to name a few.
We will further discuss new career profiles in the field of biochemistry with industry professionals. We will provide additional career resources, highlight potential jobs along with answering any and all your questions.
Activities & Credits
Scientific Poster
Students learn to make high quality science posters & hone their presentation skills.
Research Report Manuscript
Learn to draft scientific write-ups with clear and convincing narratives.
Certificates
Outstanding students also get opportunities for long-term projects with mentors.
Recent Student Projects
Targeting the Bacterial Cell Wall
https://elioacademy.org/lavanya-srinivasarangan

Lavanya Srinivasarangan
(Bridgewater-Raritan RHS)
Amoxicillin and Penicillin V are antibiotics used to fight bacterial infections. They are both part of the same antibiotic family. Amoxicillin is semisynthetic, while Penicillin V is a natural penicillin with a narrower spectrum. They both work by inhibiting bacterial cell wall synthesis. Both of these drugs are prescribed for pneumonia, bronchitis, strep throat, ear infections, among others.
Liraglutide for Diabetes & Obesity
https://elioacademy.org/abigail-lin

Abigail Lin
(Monta Vista High School)
Liraglutide is used to treat Type 2 Diabetes Mellitus by helping to lower blood sugar levels. It is a GLP-1 receptor agonist and polypeptide that binds to the GLP-1 receptors of the cells in the intestine and pancreatic beta cells.
Proton pump inhibitors (PPIs) for gastroephageal reflux
https://elioacademy.org/vytis-dauksevicius

Vytis Dauksevicius
(Westbourne School Penarth)
The structural acitivity differences between two common examples of protein pump inhibitors omeprazole and esomeprazole and study how these differences affect pharmacodyamics and pharmacogenetics.
Study on a critical antibiotic: Ciprofloxacin
https://elioacademy.org/ayush-desai
Ayush Desai
(Piscataway High School)
Ciprofloxacin is a fluoroquinolone antibiotic that has long been used to treat infections such as UTIs, pneumonia, skin infections, and anthrax exposure. It works by interfering with bacterial DNA replication and binding to the enzymes DNA gyrase and topoisomerase IV to ultimately kill the bacteria.
Precision Medicine for Cancer
https://elioacademy.org/khushie-mandhana

Khushie Mandhana
(Jamnabai Narsee International School)
The trajectory of precision medicine is preferred over traditional cytotoxic chemotherapy. Each individual's genetic makeup is unique, and designing a personalized treatment that is tailored according to the needs of the patient, remains to be the cornerstone of targeted therapy. Drugs like Imatinib are the prime examples of precision oncology.
Balancing Anti-Inflammatory Efficacy and Toxicity in Rheumatoid Arthritis
https://elioacademy.org/yi-ke-wu

Yi Ke Wu
(Appleby College)
Methotrexate is a disease-modifying antirheumatic drug (DMARD) used to treat RA and can also be used at higher doses for various cancers. Rheumatoid arthritis is a chronic autoimmune disease that causes inflammation with common symptoms in the joint. The research mainly focuses on the dual mechanisms of methotrexate in both its anti-inflammatory and toxic effects.
Genetic Polymorphisms & Personalized Therapy
https://elioacademy.org/iraj-gupta

Iraj Gupta
(Global Indian International School)
Exploring the potential for pharmacogenetic-guided personalised therapy in the management of type 2 diabetes (T2DM), a chronic metabolic disease affecting over 1 in 9 adults worldwide. It focuses on a key challenge in type 2 diabetes treatment, that is, inter-individual variability in drug response.
Mechanisms of resistance to imatinib in Chronic Myelod Lukemia
https://elioacademy.org/kayla-kerr

Kayla Kerr
(Campion College)
Imatinib is a tyrosine kinase inhibitor used to treat a number of leukemias, myelodysplastic/myeloproliferative disease, systemic mastocytosis, hypereosinophilic syndrome, dermatofibrosarcoma protuberans, and gastrointestinal stromal tumors. It is a small molecule kinase inhibitor that revolutionized the treatment of cancer, deemed as a 'miracle drug' due to its clinical success
Targeting Glucose Metabolism & Transport for Cancer Treatment
https://elioacademy.org/ishita-yadav

Ishita Yadav
(Amador Valley High School)
Cancer cells alter their metabolism to support uncontrolled growth and proliferation. Unlike normal cells, cancer cells rely heavily on glycolysis, even in the presence of oxygen, a phenomenon known as the Warburg Effect. The study highlights the potential of targeting glucose metabolism as a therapeutic strategy in cancer treatment.
Phenylketonuria (PKU)
https://elioacademy.org/francesca-gomez

Francesca Chevarría Gómez
(Max Uhle Peruvian-German School)
Phenylketonuria (PKU) is an autosomal recessive genetic disorder, which means, two copies of the mutation must be present for the disease to develop. PKU can be caused by 400 different known variants in the PAH gene. The phenylalanine hydroxylase (PAH) enzyme performs the breakdown of the amino acid phenylalanine (phe) into tyrosine (Tyr), which is required by the body to produce stress neurotransmitters such as epinephrine, norepinephrine and dopamine.

Want to Work on Your Own Project?
Apply to ELIO mentored projects in Genetics, Neuroscience, Medical Data Science, Biochemistry,